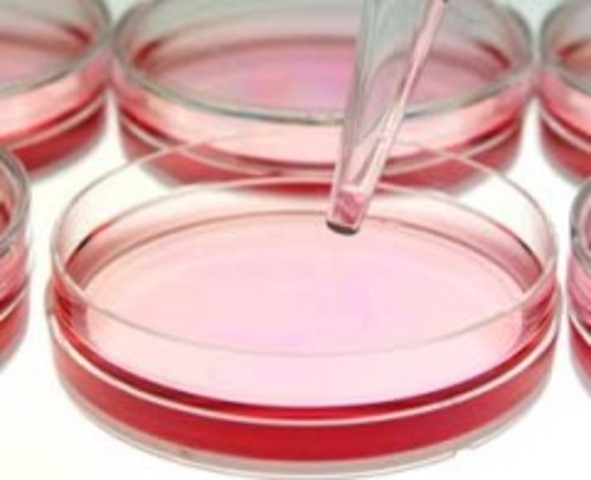
Invensión de la Cajas Petri - Julius Richard Petri

-
Hooke descubrió las células observando en el microscopio una lámina de corcho, dándose cuenta de que estaba formada por pequeñas cavidades poliédricas que recordaban a las celdillas de un panal. Por ello cada cavidad se llamó célula. No supo demostrar lo que estas celdillas significaban como constituyentes de los seres vivos. Lo que estaba observando eran células vegetales muertas con su característica forma poligonal.
-
Demostró que los insectos no nacen por generación espontánea, por lo que se le considera el fundador de la helmintología
-
Fue la primera persona en observar bacterias y otros tipos de organismos, descubrió que en una gota de agua de estanque pululaba una asombrosa variedad de pequeñas criaturas a las que denominó "animálculos"
-
Pasteur opinaba que el origen y evolución de las enfermedades eran semejantes a los procesos de fermentación. Es decir, la enfermedad surge por el ataque de gérmenes que están fuera del organismo, igual que los microorganismos no deseados invaden la leche y causan su fermentación.
-
Demostró que todo proceso de fermentación y descomposición orgánica se debe a la acción de organismos vivos y que el crecimiento de los microorganismos en caldos nutritivos no era debido a la generación espontánea.
-
Fue un microbiólogo alemán a quien se le atribuye la invención de la placa de Petri, utilizada para los cultivos bacterianos, mientras trabajaba como asistente de Robert Koch.
-
En 1882 un médico prusiano, Robert Koch, emplea un novedoso método de tinción y lo aplica a muestras de esputo procedentes de pacientes con tuberculosis, revelándose por primera vez el agente causante de la enfermedad: el Mycobacterium tuberculosis, o bacilo de Koch, en su honor.
-
Charles Louis Alphonse Laveran fue un médico y naturalista francés, ganador del premio Nobel de Medicina en 1907, por su descubrimiento de los parásitos protozoarios como agente causal de enfermedades infecciosas como la malaria y tripanosomiasis.
-
Hans Christian Joachim Gram fue un bacteriólogo danés quien en 1884 desarrolló la tinción de Gram, de amplio uso en microbiología.
-
En 1887, investigó una enfermedad que afectaba el tabaco que denominó contagium vivum fluidum. En 1892, observó otra afección de las plantas del tabaco, y descubrió que ambas enfermedades estaban causadas por un agente microscópico capaz de impregnar los filtros de la porcelana, algo que las bacterias nunca podrían hacer. Ivanovski pensó que su filtro era imperfecto, y que el microorganismo había pasado a través de pequeños orificios existentes.
-
En 1915 descubrió los bacteriófagos, virus capaces de atacar y destruir diversas bacterias de forma específica.
-
Gracias en gran parte a su inclinación de tener un laboratorio sucio. El bacteriólogo británico y Premio Nobel Sir Alexander Fleming descubrió el antibiótico más utilizado en el mundo, la penicilina.
-
Físico neerlandés ganador del premio Nobel de Física en 1953 por su invención del microscopio de contraste de fases.
-
Ernst Ruska fue el inventor del microscopio electrónico , y más tarde ganador de un Premio Nobel por su hazaña.
-
La Escuela de Ciencias Biológicas nace el 19 de septiembre de 1952 bajo el amparo del Instituto de Investigaciones Científicas de la. Facultad de Filosofía, Ciencias y Letras de la Universidad de Nuevo León. Su fundador fue el Dr. Eduardo Aguirre Pequeño.
-
En 1965 se establece un nuevo plan de estudios de Biólogo Bacteriólogo Parasitólogo en la Facultad de Ciencias Biologicas
-
El plan de estudios de Biólogo Bacteriólogo Parasitólogo se modifica en 1968 y da lugar a la carrera de Químico Bacteriólogo Parasitólogo.
Plan projects on a visual timeline
Map milestones, phases, deadlines, and key events in one place so the sequence is easier to see and share. Timetoast is a timeline maker for work, school, research, and stories.